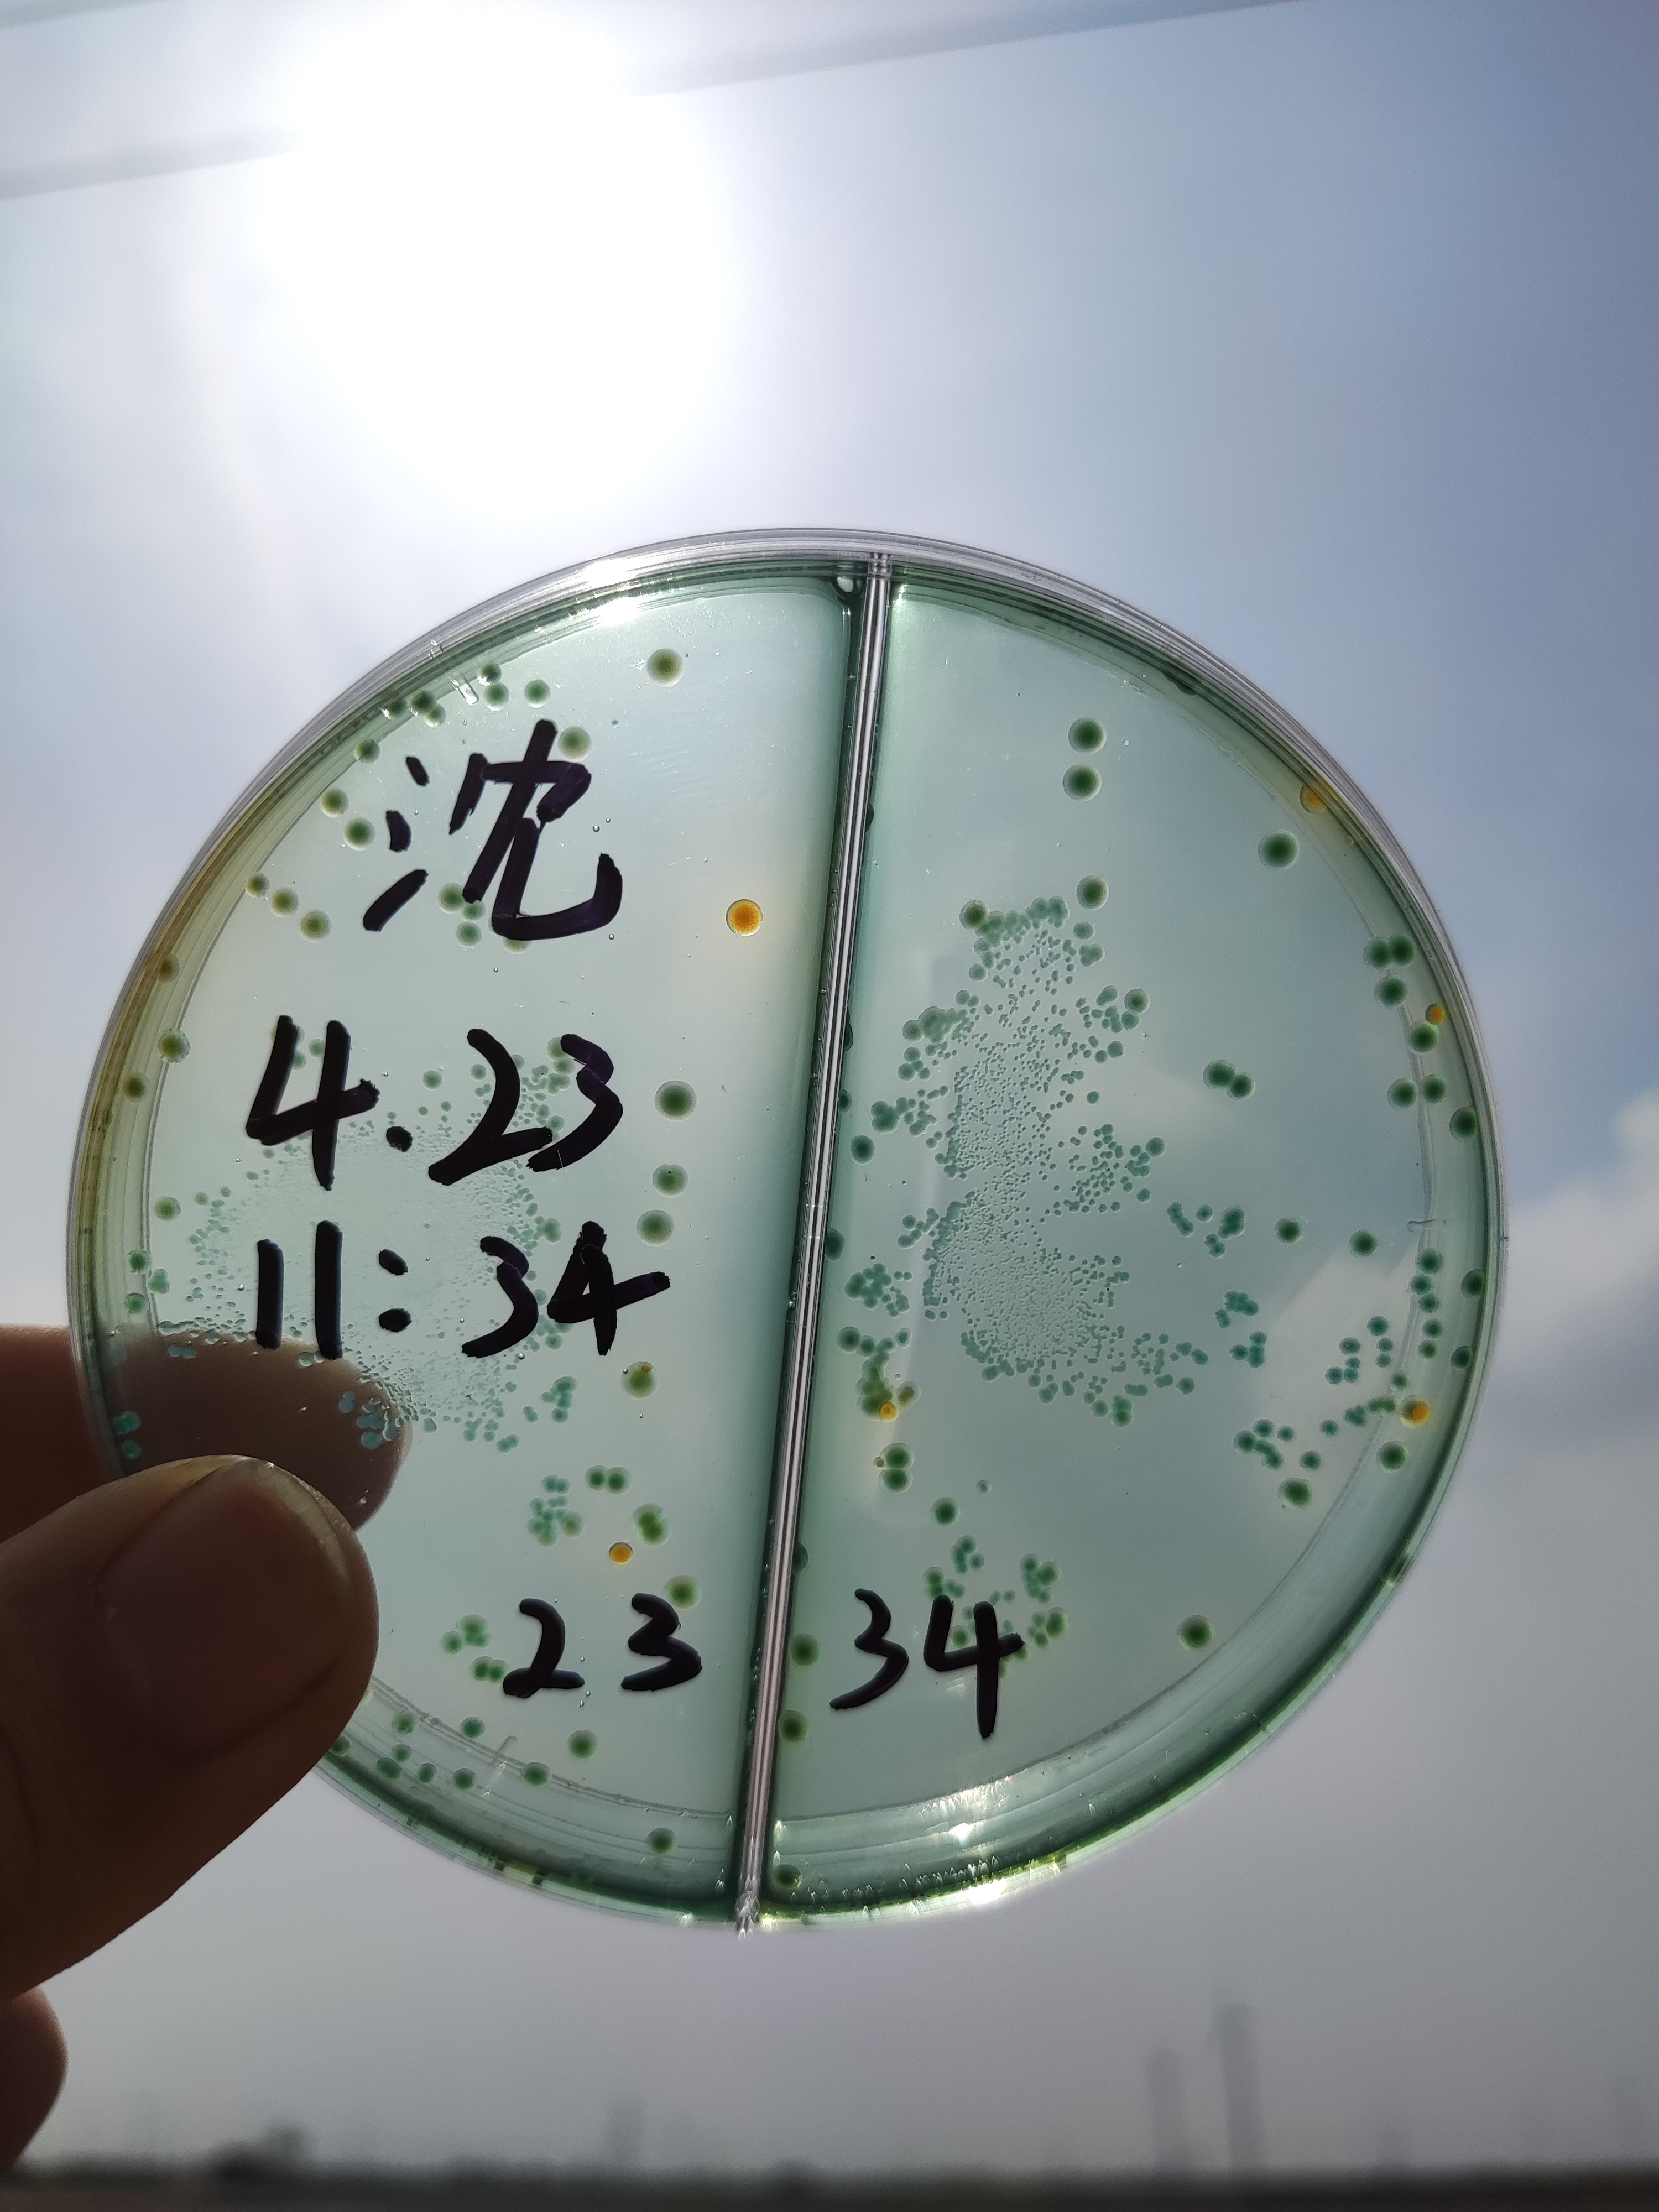
南美白对虾绿弧菌的处理案例
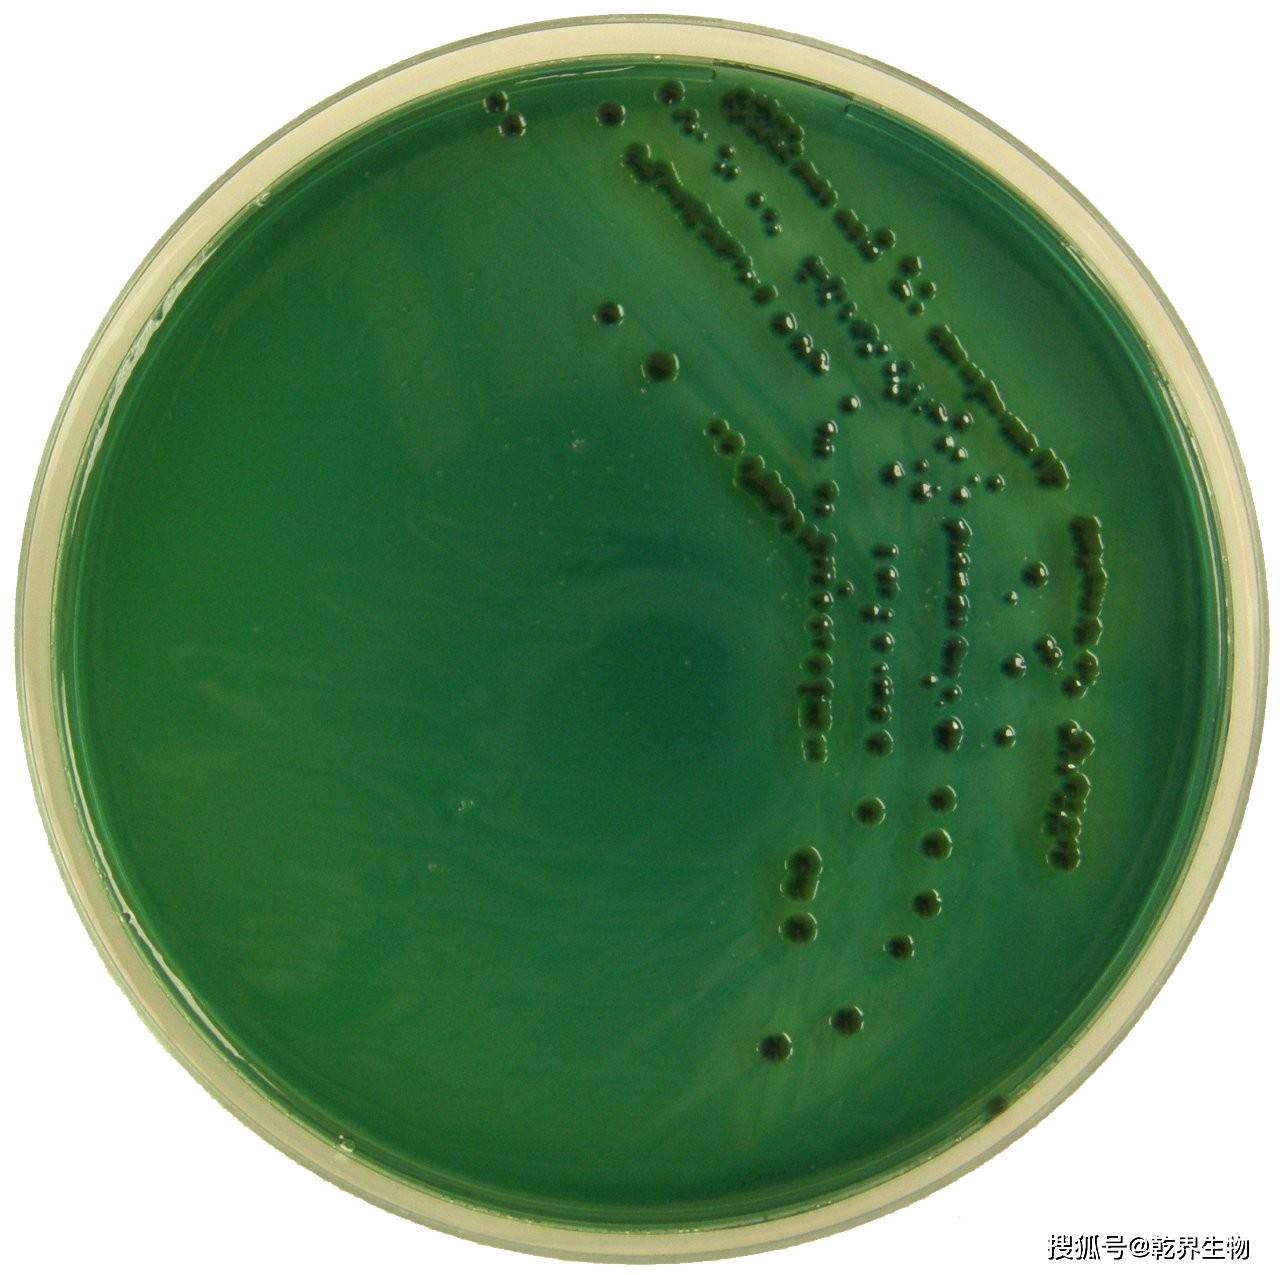
绿弧菌对虾的影响
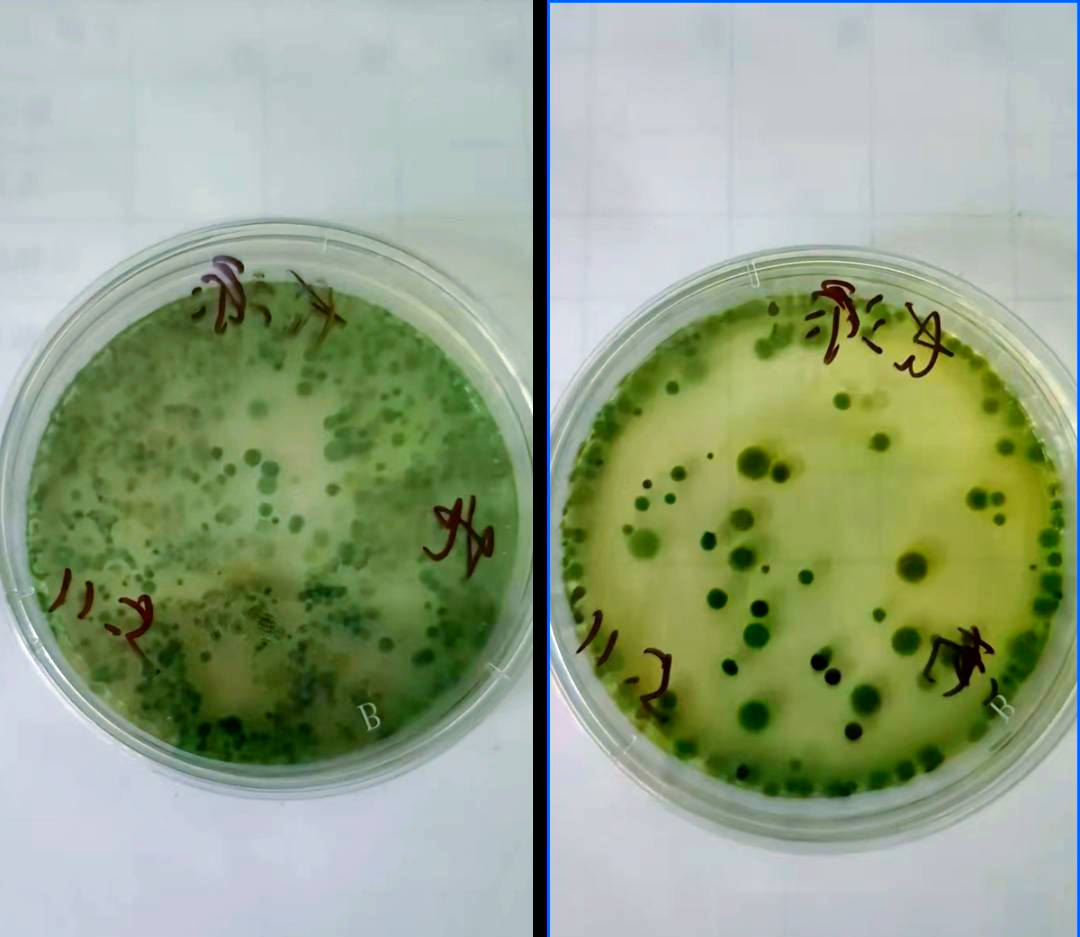
若培养皿上黄弧菌数量在10个以内,绿弧菌数量在5个以内,则可视为相对
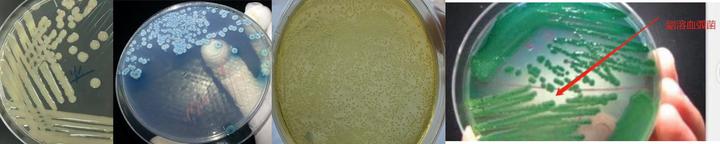
绿弧菌和黄弧菌:虾类养殖的双重挑战与防控策略

绿弧菌图片

绿弧菌已成对虾养殖拦路虎!2022对虾养殖如何高效防控?
图片尺寸1080x754
弧菌培养基培养出来的绿弧菌包括溶血和溶藻?
图片尺寸1944x2592
虾塘绿弧菌可怕还是黄弧菌可怕,南美白对虾黄弧菌绿弧菌的危害
图片尺寸1052x591
南美白对虾绿弧菌的处理案例
图片尺寸3000x4000
本草虾宝处理水体绿弧菌迅速见效纯中药提取物适合弱身不宜情况
图片尺寸1920x1080
绿弧菌对虾的影响
图片尺寸1280x1275
弧菌检测.绿弧菌要全程控制,定期防范,特别是蜕壳期,切莫大意
图片尺寸1440x1920
香连➕金苓处理绿弧菌#绿弧菌
图片尺寸1284x2420
若培养皿上黄弧菌数量在10个以内,绿弧菌数量在5个以内,则可视为相对
图片尺寸1080x937
弧菌vibrio 绿色荧光标记菌株
图片尺寸4000x3000
弧菌.没涂好黄弧菌和绿弧菌
海水土塘中黄弧菌
图片尺寸2880x2160
控弧卫士针对水体黄绿弧菌,各种有害菌,不伤水体不伤藻!72小
图片尺寸1080x1919
防控弧菌.绿弧菌防控是贯穿养殖全程,改底塘底与水质, 减少滋
图片尺寸1440x1920
文哥;使用之前:发现有几只虾游塘,提罾有三十多只偷死,检测绿弧菌爆屏
图片尺寸1045x697
可导致对虾致病的弧菌种类很多,常见的绿弧菌有:副溶血弧菌,创
图片尺寸1080x1440
绿弧菌和黄弧菌:虾类养殖的双重挑战与防控策略
图片尺寸720x144
绿弧菌超标.天气多变,又在换壳期,弧菌超标危害大,每日改底
图片尺寸1440x1920
给你一份弧菌的科普知识,赶快看看吧
图片尺寸640x1138
弧号——弧菌的克星⭐ 针对: 绿 弧菌,黄 弧菌
图片尺寸1080x1234
晓燊弧无影在水产养殖中捕食裂解黄弧菌绿弧菌高致弧菌等弧菌细菌 单
图片尺寸1500x1500